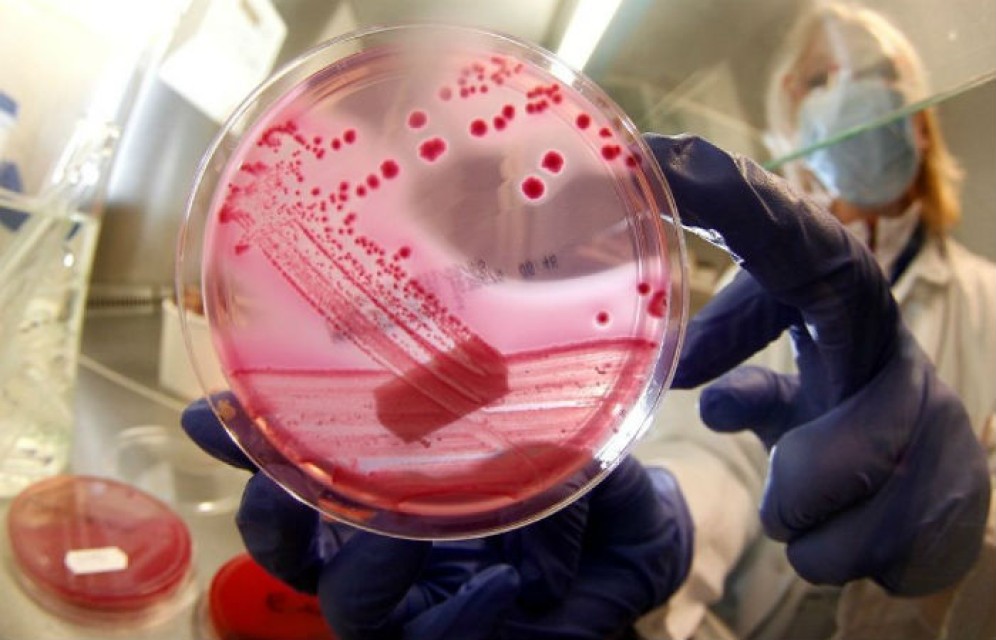
Жителей Хакасии атакуют кишечные инфекции

Жителей Хакасии атакуют кишечные инфекции
За прошедшую неделю в Хакасии зарегистрировано 105 случаев заболеваний острыми кишечными инфекциями, что выше среднемноголетнего уровня на 28%. Среди жителей Абакана зарегистрировано 50 случаев заболеваемости кишечными инфекциями, что выше среднемноголетнего уровня на 52%. Из общего числа заболевших 35% приходится на взрослое население.
Установлено, что более половины заболевших отдыхали на природе, где употребляли в пищу скоропортящиеся продукты (шашлыки, готовые кулинарные изделия, яйца), которые хранились без соблюдения температурного режима. Так же отмечалось употребление некачественно обработанных овощей и фруктов, нарушение правил личной гигиены. Среди взрослого населения нередки случаи употребления алкогольных напитков, в т.ч. разливного пива, сообщает региональное Управление Роспотребнадзора.
Похожие новости











